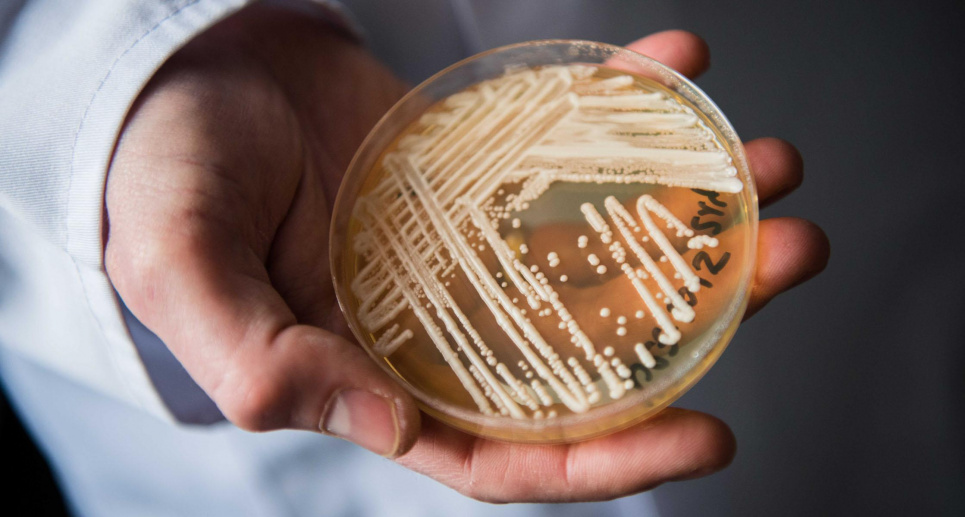

Не поддающийся лечению грибок: новая угроза для больниц Европы
В настоящее время зарегистрировано уже более 4000 зараженных за последние 10 лет.
Европейское агентство по здравоохранению предупреждает о «быстром» распространении в больницах Европы грибка, не поддающегося лечению. За последние десять лет было зафиксировано более 4000 случаев инфицирования, — Euronews.
Новая угроза для пациентов
Грибок Candidozyma auris (ранее известный как Candida auris) легко распространяется в медицинских учреждениях и часто устойчив к лекарствам, предназначенным для его уничтожения. По данным нового отчета Европейского центра по профилактике и контролю заболеваний (ECDC), инфекции могут быть особенно опасными для пациентов с ослабленным здоровьем.
С 2013 по 2023 год в странах Европейского Союза и соседних государствах было зарегистрировано более 4000 случаев заражения, причем количество случаев значительно возросло со временем. В 2023 году грибок был выявлен в 18 странах.
Больше всего случаев зафиксировано в Испании, Греции, Италии, Румынии и Германии. Последние вспышки также были зарегистрированы на Кипре, во Франции и Германии.
По словам Диамантиса Плахураса, руководителя отдела ECDC по вопросам устойчивости к антимикробным препаратам, в некоторых частях Европы C. auris стал настолько распространенным, что «почти стал эндемичным в больничных условиях».
Почему так трудно бороться?
Главная опасность грибка заключается в его способности выживать на различных поверхностях и медицинском оборудовании, а также быстро передаваться от пациента к пациенту. Не все распространенные дезинфицирующие средства эффективны против него, что делает обычную дезинфекцию недостаточной для предотвращения распространения.
Симптомы инфицирования C. auris не являются специфическими — это может быть лихорадка, озноб или другие проявления, в зависимости от пораженного участка тела (например, крови, раны или ушей). Для точного выявления требуется лабораторное тестирование.
Путь распространения
C. auris впервые выявили в Японии в 2009 году. После первого появления в стране ему потребовалось лишь несколько лет, чтобы получить широкое распространение. По словам господина Плахураса, обычно грибок попадает в новую страну, когда пациент был госпитализирован за границей, где C. auris уже присутствовал.
ECDC призывает страны и системы здравоохранения усилить меры раннего выявления и контроля, чтобы остановить распространение грибка.
«Это крайне беспокоит и безусловно представляет угрозу для безопасности пациентов в больницах по всей Европе», — подытожил Диамантис Плахурас.
Больше новостей читайте на GreenPost.







